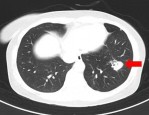
浙江杭州女子整理衣柜后病倒，竟是肺部长满菌斑高烧40℃

2024年研究:睡眠时灯光或增阿兹海默风险,虽未定论但提供新思路
或许,居住在城市的你,总是享受早上被阳光唤醒的清晨,但是夜间不得不和窗外照进来的灯光相伴;又或许,总是起夜的你,习惯留一盏夜灯,为你提供方便。
但是 2024 年 9 月发表于《神经科学前沿》的一项研究表明,这些在你睡眠时与你相伴的光线不仅会影响你休息,还可能会增加阿尔兹海默症的风险。不过需要注意的是,这篇研究目前只是个前沿性的研究,所以只是提出了这种可能性,还不能得出确切的结论,但是为进一步了解阿尔兹海默症、降低阿尔兹海默症风险提供了新思路。
光污染与阿尔兹海默症风险
显著相关
这项研究的科研人员把美国 48 个州的光污染情况和本地区的医疗记录进行了比对,令人惊讶的是,他们竟然发现光污染和阿尔兹海默症之间存在显著正相关,这种巧合也引起了科研人员的兴趣。

美国各大州光污染程度和阿尔兹海默症患病情况
他们继而对被影响到的群体进行了更细致的划分,对于 65 岁以上的人,阿尔兹海默症的风险因素包括酗酒、慢性肾病、抑郁症、糖尿病和高血压,光污染程度只是其中的风险因素之一。
而对于 65 以下的人群,在研究中评估的众多因素中,光污染程度可能是影响阿尔兹海默症患病风险的第一大因素。不过需要注意的是,这只能证明光污染和阿尔兹海默症存在相关关系,并不能证明其因果关系。
光污染怎样影响我们的身体?
那么,光污染会怎么影响到我们的身体的呢?为了探究这个问题,研究人员把 20 名参与者分别安排在昏暗的房间以及开灯的房间中入眠,在夜间同步监测他们的心率。
结果表明,在开灯的房间中入眠的受试者心率更快,意味着他们的交感神经系统被过度激活了,心肌收缩力增加,血流的速度加快,本应该在夜晚中得到充分休息的身体在夜晚依然没有得到安宁,而这一切仅仅是因为他们暴露在光照的环境下度过了一夜。

光照以及昏暗环境下受试者的心率
在他们醒来之后,研究人员也会检测他们的胰岛素分泌情况,结果表明他们的胰岛素抵抗增加,原本的葡萄糖平衡被打破了,这增加了糖尿病的风险。
有研究人员将大鼠暴露在夜间光照的环境下,3~8 周之后,他们发现这些大鼠的海马神经元的树突棘密度降低,相关行为学实验也表明,这些大鼠变得抑郁了,丧失了获得快乐的动力。所以,光污染的破坏力可能远超我们的想象。
光污染会导致失眠
失眠可能会加重阿尔兹海默症
除此之外,光污染对我们最直接的影响就是会导致失眠。在韩国一项调研光污染和失眠的实验中,52000 名受试者中约有 22%服用失眠类药物,而光污染的程度越严重,其中服用失眠药物的比例越高。这是因为大脑中的松果体可以感受光亮,当光照充足时,就会抑制褪黑素的分泌,扰乱昼夜节律会让人失眠。
而失眠与阿尔兹海默症的联系是非常紧密的,有研究人员选取了 511 名受试者进行基本检测,在 4 年后再对他们进行复查,结果表明,失眠症状越严重,在随后的认知检测中他们的表现会更差,而这在 APOE ε4(阿尔兹海默症风险基因)等位基因携带者中尤为明显,这表明当大脑已经容易受到神经退行性变的影响时,失眠可能特别有害,属实是雪上加霜了。
需要再次强调的是,这项研究还在探索阶段,并未盖棺定论,大家看看就好。但是这个有意思的研究,为阿尔兹海默症研究提供了新的思路,或许我们有一天能更深入了解这项疾病,帮助更多人远离阿尔兹海默症。
不过话说回来,光污染确实会导致失眠,尤其是对于睡眠不好的人群来说,还是建议大家睡觉时能够保持黑暗的睡眠环境。
相关文章
猜你喜欢
-
浙江杭州女子整理衣柜后病倒,竟是肺部长满菌斑高烧40℃
“全身不舒服,发热,体温最高到了40℃,还咳嗽……” 近期,杭州某位女士在整理衣柜时感到身体不适,遂前往医院检查,结果令人惊讶,原来问题出在肺部“发霉”上,这背后究...
-
武汉举行大型义诊活动,200 余位专家为市民提供诊疗服务
极目新闻记者 曹洋 活动现场 9月28日,武汉解放公园嘉卉广场熙熙攘攘,人声鼎沸。由湖北省卫健委、武汉市卫健委主办,武汉市第四医院(湖北省运动医学中心)承办的“武...
-
凉拌海带丝的小诀窍,实惠营养又健康,快来试试吧
当然了这是一句玩笑话,饭店的大厨都有自己的一套配菜以及配料标准,每一个人做出的口味都不一样,就算我们用饭店大厨一样的配菜,同学比例的配料做出的味道也是不一样的。所以...